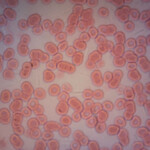

Application
Home > Application
Industry
Over the past eight years, the Dino-Lite digital microscope has helped users around the world increase their productivity in a wide range of mundane to mission-critical applications. Due to its superior image quality, compact form factor, and ease-of-use, this product has quickly risen to a dominant position in the marketplace. From its initial success, the product line has expanded to include hundreds of models ( and accessories) to fulfill specific customer needs. As a result, the Dino-Lite microscope is now an indispensable tool in multiple market sectors, such as academics, manufacturing, quality control, healthcare, and education.
Application sample
Manufacturing / Engineering integration / Quality Control / Assembly / Printing / Reparing / Inspection / Textile / PCB/IC / LCD/Solar Panel / Agriculture / Automotive / Printing
Science & Education
Over the past eight years, the Dino-Lite digital microscope has helped users around the world increase their productivity in a wide range of mundane to mission-critical applications. Due to its superior image quality, compact form factor, and ease-of-use, this product has quickly risen to a dominant position in the marketplace. From its initial success, the product line has expanded to include hundreds of models ( and accessories) to fulfill specific customer needs. As a result, the Dino-Lite microscope is now an indispensable tool in multiple market sectors, such as academics, manufacturing, quality control, healthcare, and education.
Application sample
Education / Lab/Research / Life science / Training / Entomology / Plants/ Botany / Archaeology / Minerology / Paleontology / Material Science / Ecology
Health Care
Over the past eight years, the Dino-Lite digital microscope has helped users around the world increase their productivity in a wide range of mundane to mission-critical applications. Due to its superior image quality, compact form factor, and ease-of-use, this product has quickly risen to a dominant position in the marketplace. From its initial success, the product line has expanded to include hundreds of models ( and accessories) to fulfill specific customer needs. As a result, the Dino-Lite microscope is now an indispensable tool in multiple market sectors, such as academics, manufacturing, quality control, healthcare, and education.
Application sample
Dermatology / Nail Circulation / Iridology / Trichology / Laboratory / Veterinary
Forensic
Over the past eight years, the Dino-Lite digital microscope has helped users around the world increase their productivity in a wide range of mundane to mission-critical applications. Due to its superior image quality, compact form factor, and ease-of-use, this product has quickly risen to a dominant position in the marketplace. From its initial success, the product line has expanded to include hundreds of models ( and accessories) to fulfill specific customer needs. As a result, the Dino-Lite microscope is now an indispensable tool in multiple market sectors, such as academics, manufacturing, quality control, healthcare, and education.
Application sample
Law enforcement / Counterfeit
Jewelry
Over the past eight years, the Dino-Lite digital microscope has helped users around the world increase their productivity in a wide range of mundane to mission-critical applications. Due to its superior image quality, compact form factor, and ease-of-use, this product has quickly risen to a dominant position in the marketplace. From its initial success, the product line has expanded to include hundreds of models ( and accessories) to fulfill specific customer needs. As a result, the Dino-Lite microscope is now an indispensable tool in multiple market sectors, such as academics, manufacturing, quality control, healthcare, and education.
Application sample
Hobbies / Jewelry / Coins / Stamps / Antiques / Art restoration / Culture preservation